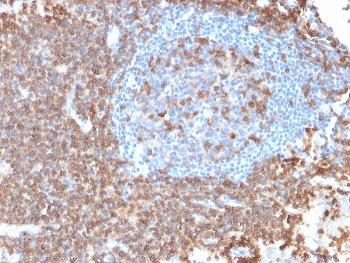
Recombinant CD43 Antibody

You have no items in your shopping cart.
Recombinant CD43 Antibody
Description
Research Area
Images & Validation
−| Tested Applications | FACS, IF, IHC-P, WB |
|---|---|
| Dilution Range | Flow cytometry: 1-2ug/10^6 cells,Western blot: 1-2ug/ml,Immunofluorescence: 1-2ug/ml,Immunohistochemistry (FFPE): 1-2ug/ml for 30 min at RT |
| Reactivity | Human |
| Application Notes |
Key Properties
−| Antibody Type | Primary Antibody |
|---|---|
| Host | Mouse |
| Clonality | Recombinant |
| Isotype | Mouse IgG1, kappa |
| Clone No. | rSPN/839 |
| Immunogen | Recombinant human protein was used as the immunogen for the recombinant CD43 antibody. |
| Purification | Protein G affinity chromatography |
| Conjugation | Unconjugated |
Storage & Handling
−| Storage | Maintain refrigerated at 2-8°C for up to 2 weeks. For long term storage store at -20°C in small aliquots to prevent freeze-thaw cycles. |
|---|---|
| Buffer/Preservatives | 0.2 mg/ml in 1X PBS with 0.1 mg/ml rAlbumin and 0.05% sodium azide |
| Expiration Date | 12 months from date of receipt. |
| Disclaimer | For research use only |
Similar Products
−Recombinant CD43 Antibody [orb606475]
FACS, IF, IHC-P, WB
Human
Mouse
Recombinant
Unconjugated
20 μg, 100 μgRecombinant CD43 Antibody / Rabbit Monoclonal [orb2640366]
FACS, IF, IHC-P, WB
Human
Rabbit
Recombinant
Unconjugated
100 μgRecombinant CD43 Antibody / Rabbit Monoclonal [orb2640793]
FACS, IF, IHC-P, WB
Human
Rabbit
Recombinant
Unconjugated
100 μg

Quality Guarantee
Explore bioreagents carefree to elevate your research. All our products are rigorously tested for performance. If a product does not perform as described on its datasheet, our scientific support team will provide expert troubleshooting, a prompt replacement, or a refund. For full details, please see our Terms & Conditions and Buying Guide. Contact us at support@biorbyt.com.

Western blot testing of human K562 cell lysate with recombinant CD43 antibody (clone rSPN/839). Expected molecular weight: 45-135 kDa depending on glycosylation level.
IHC testing of FFPE human lymph node with recombinant CD43 antibody (clone rSPN/839). Required HIER: boil tissue sections in pH9 10mM Tris with 1mM EDTA for 10-20 min followed by cooling at RT for 20 min.

Immunofluorescence staining of human K562 cells with recombinant CD43 antibody (green, clone rSPN/839) and Reddot nuclear stain (red).

Flow cytometry testing of human K562 cells with recombinant CD43 antibody (clone rSPN/839); Red = isotype control, Blue = CD43 antibody.

SDS-PAGE analysis of purified, BSA-free recombinant CD43 antibody (clone rSPN/839) as confirmation of integrity and purity.
Quick Database Links
UniProt Details
−Documents Download
Request a Document
Protocol Information
Recombinant CD43 Antibody (orb606476)
Participating in our Biorbyt product reviews program enables you to support fellow scientists by sharing your firsthand experience with our products.
Login to Submit a Review


























